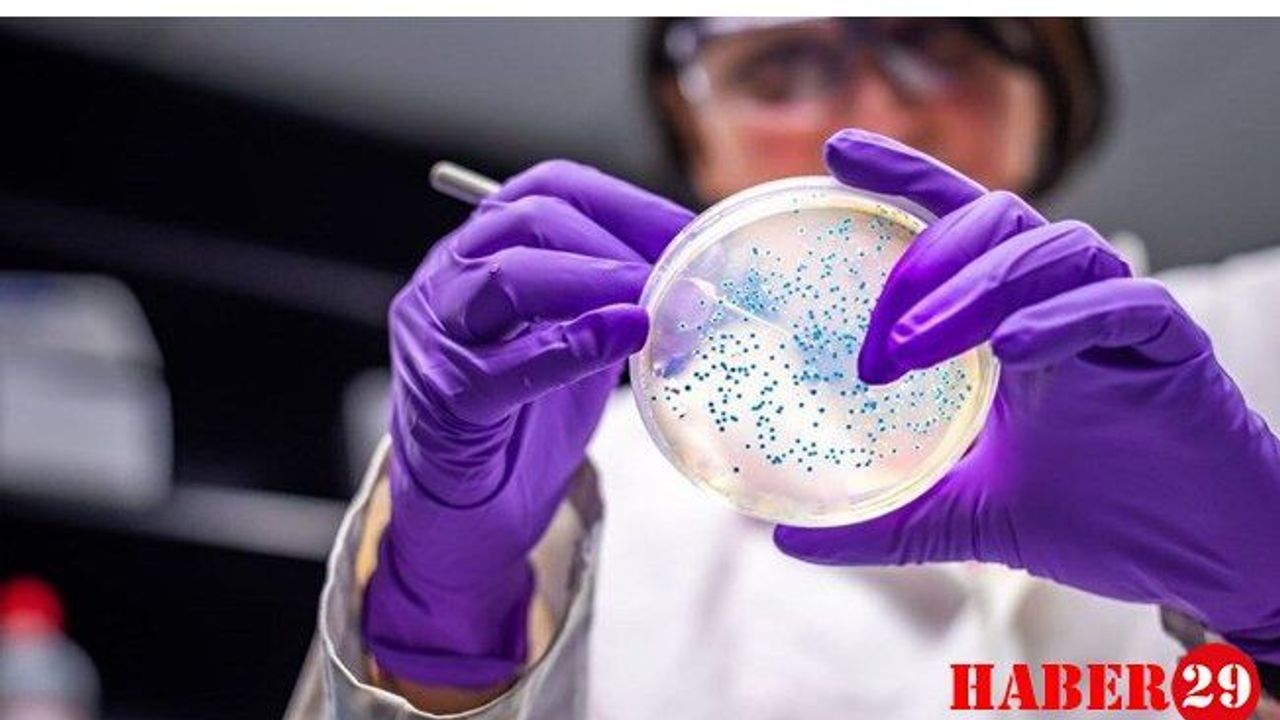

Japonya'da 396 kişi, Covid-19'un "daha önce görülmemiş" yeni bir türüne yakalandı.
Japonya'da, 396 kişinin, yeni tip corona virüsün (Covid-19) "daha önce görülmemiş" yeni bir türüne yakalandığı bildirildi.
Salgın Hastalıkları Ulusal Enstitüsü (NIID), 396 kişinin, daha önce İngiltere, Güney Afrika ve Brezilya'da rastlanan türlerin dışında, yeni bir Covid-19 varyantına yakalandığını açıkladı.
Vakaların, başkent Tokyo'nun bulunduğu Kanto bölgesinde tespit edildiği kaydedildi.
NIID'ye göre, söz konusu ülkelerdeki türlerle bazı benzerlikler taşıyan varyantın, yeniden bulaşma riskini artırabileceğinden ve mevcut Covid-19 aşılarının etkisini düşürebileceğinden endişe ediliyor.
NIID'nin Acil Müdahale ve Hazırlık Merkezi Başkanı Saito Tomoya, yeni varyantın, Japonya dışından geldiğinin tahmin edildiğini, ancak yeterli seviyede bilgi sahibi olmadıklarını söyledi.
Tomoya, "Yeni türün 'ana akım' oluşturabileceğini düşünmüyoruz, ancak duruma yönelik bilgi edinmeye çalışacağız." dedi.